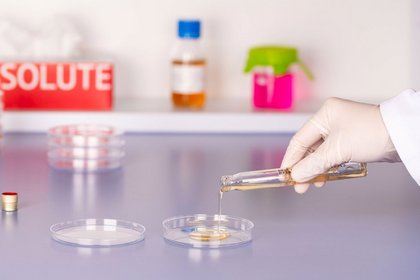
Eine behandschuhte Hand gießt flüssigen Agar aus einer kleinen Flasche in eine Petrischale im Labor

Membrane-Plate-Kits
BIOSOLUTE® für die mikrobiologische Wasseranalyse
Entdecken Sie das neue BIOSOLUTE® Portfolio für optimierte Prozesse in der Membranfiltration für die mikrobiologische Wasseranalyse. Jedes Membrane-Plate-Kit enthält 100 validierte Membranfiltrationsplatten von BIOSOLUTE® und 100 passende Membranfilter von Sartorius.
BIOSOLUTE® Membranfiltrationsplatten sind qualitativ besonders hochwertige kleinere Platten der Größe 55 mm mit 9 ml Füllvolumen.

Profitieren Sie von der Sicherheit durch zertifizierte, kombinierte Validierung der Platten und Filter
- Konform mit ISO 11133:2014
- Durchführung in einem nach ISO 17025 akkreditierten Labor
- Filter entsprechen ISO 7704:2023
- Umfangreiche kombinierte Analysenzertifikate für jede Charge inklusive Filtercharge
Sparen Sie Platz und Energiekosten – und punkten Sie hinsichtlich Nachhaltigkeit
- Am Lagerplatz: Optimierte Raumnutzung und ungekühlte Lagerbedingungen
- Im Brutschrank: Gute Stapelbarkeit der Platten
- Bei der Entsorgung: Verringertes Volumen und Gewicht
Optimieren Sie Ihre Bevorratung
- Lagerung bei Raumtemperatur
- Längere Haltbarkeit der Platten
- MHD je nach Agar 5 bis 7 Monate ab Produktionsdatum

BIOSOLUTE® Membrane-Plate-Kits sind erhältlich für verschiedene Nährmedien zur Überprüfung von wässrigen Proben durch die Membranfiltrationstechnik. Jedes BIOSOLUTE® Membrane-Plate-Kit enthält je
- 100 BIOSOLUTE® Platten für die Membranfiltration
- 100 passende Sartorius Membranfilter vom Typ 114H6--47----SCM mit Gitter
| Artikelnummer | Bezeichnung | Spezifikation |
|---|---|---|
| 8573.0100 | Chromogener Coliformer Agar (CCA) Membrane-Plate-Kit | Selektiver und differenzieller Nährboden für den Nachweis und die Auszählung von Gesamtcoliformen und E. coli in Wasserproben durch Membranfiltrationstechnik, ISO 9308 |
| 8572.0100 | Slanetz- und Bartley Agar Membrane-Plate-Kit | Differenzielles Selektivmedium für den Nachweis und die Auszählung von Enterokokken in Wasserproben gemäß ISO 7899 |
| 8571.0100 | Pseudomonas CN Cetrimid Agar Membrane-Plate-Kit | Selektives Nährmedium für den Nachweis von Pseudomonas aeruginosa in Wasser nach ISO 16266 |
| 8570.0100 | TSC Agar (Tryptose Sulfit Cycloserin Agar) | Membrane-Plate-Kit. Selektiv- und Differenzialnährmedium zur Isolation und präsumtiven Identifikation von Clostridium perfringens gemäß DIN 10165, FDA, ISO 6461-2, ISO 7927 und ISO 14189 |
* Beim Klicken auf die Artikelnummern gelangen Sie in dem Webshop.

Produktinformation Membranfilter Typ 114, Cellulosenitrat von Sartorius
Weiße Membranen mit schwarzem Gitter, zum Nachweis von Bakterien mittels farbstoffhaltiger Nährmedien, Partikelanalyse & Mikroskopie, konform ISO 7704, ISO 7899-2, ISO 8199, ISO 9308-1, DIN EN ISO 11731-2 und EN 12780.
- Exzellente Wiederfindungsraten für Mikroorganismen
- Durchmesser 47 mm, Porengröße 0,45 µm gemäß ISO 7704
- Gammabestrahlt mit 25 kGray
- Einzeln, steril verpackt, zur Verwendung mit Spender
- Qualitätszertifikat für jede Charge
Analysezertifikate für BIOSOLUTE® Membrane-Plate-Kits
In den Analysezertifikaten für BIOSOLUTE® Membrane-Plate-Kits finden Sie alle erforderlichen Informationen rund um das Produkt und die Validierung.
Diese umfassen
- Artikelnamen, Artikelnummer und Chargennummer
- Umfang des Inhalts
- Produktionsdatum und Haltbarkeitsdatum
- Zusammensetzung
- Physikalisch-chemische Daten zu Inhalt, Farbe und pH-Wert
- Steriltestung, Bedingungen und Ergebnis
- Performance Testung, Testspezifikationen, Referenzstämme und Ergebnis
- Freigabedatum
Die Validierung und Testung der mikrobiellen Leistung erfolgt in einem nach UNE EN ISO/IEC 17025 akkreditierten Labor und erfüllt die Anforderungen der Norm ISO 11133.
Haben Sie Fragen zu unseren Produkten? Wir sind gerne für Sie da! Kontaktieren Sie uns per E-Mail oder über unser Kontaktformular – wir melden uns umgehend bei Ihnen und beraten Sie persönlich.